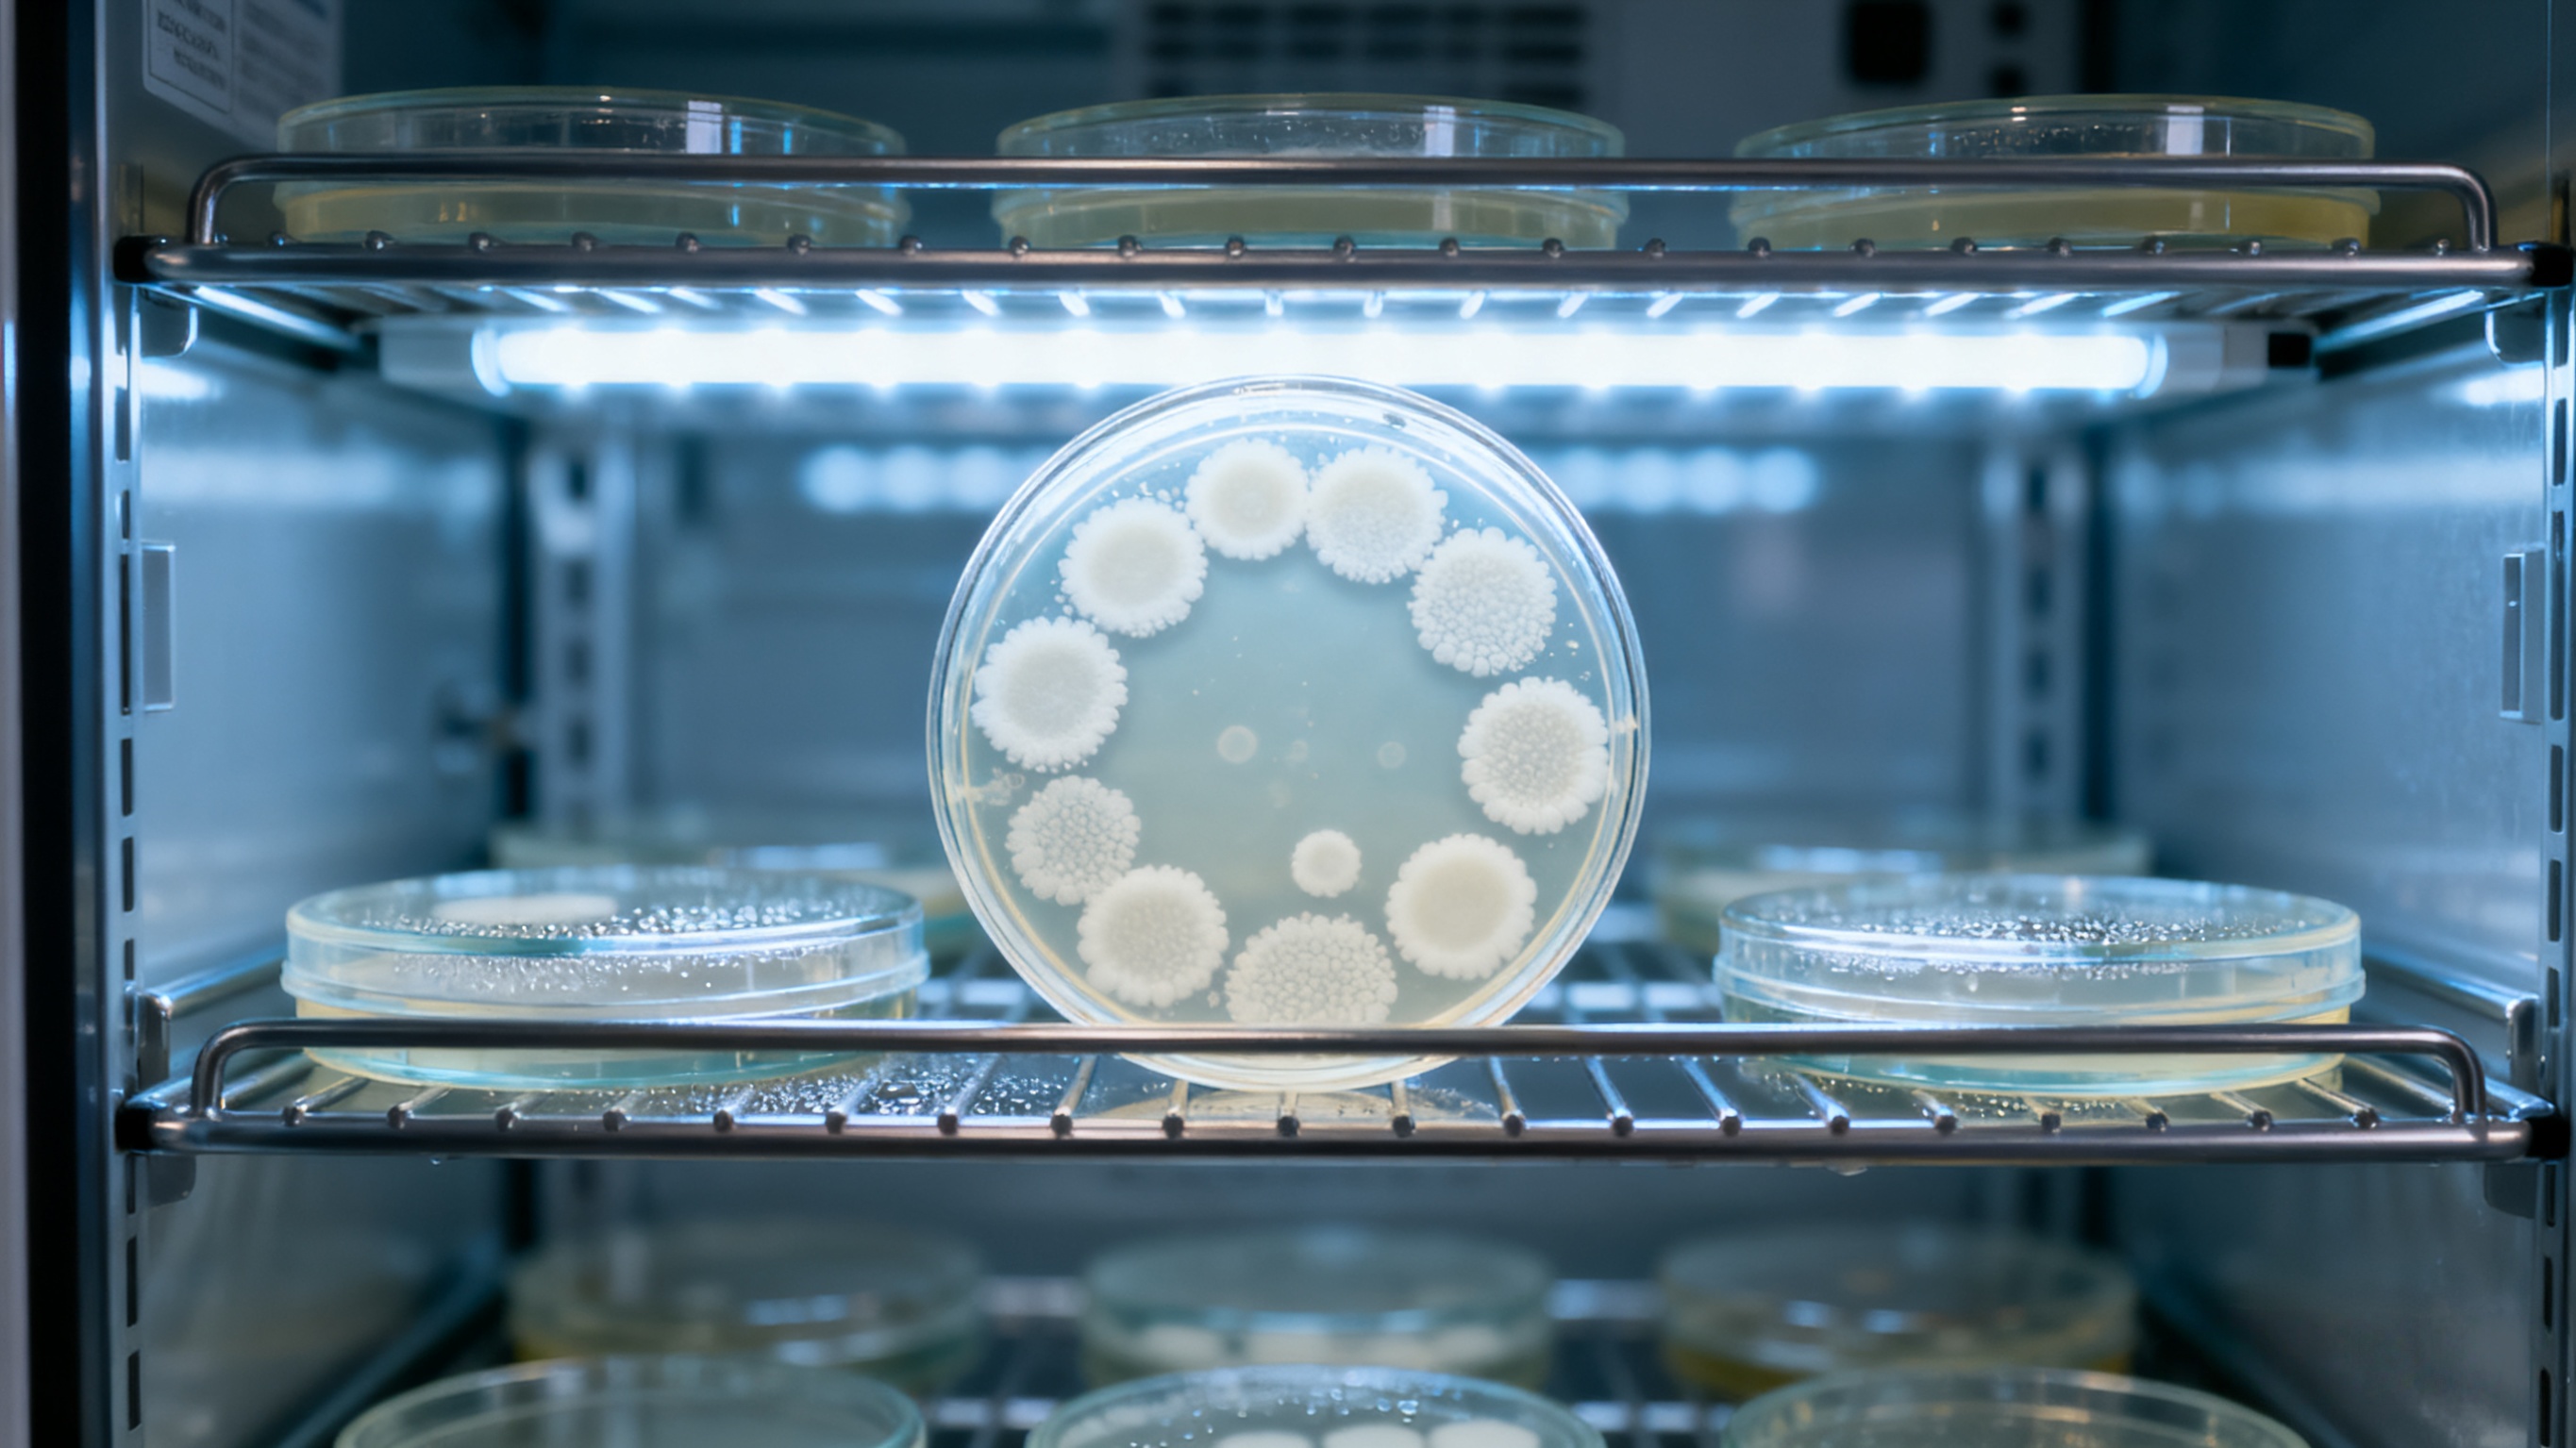

口服NAD+只是心理安慰?注射级技术如何重塑千亿抗衰市场格局
在2018年哈佛大学的一场学术研讨会上,衰老生物学专家David Sinclair教授展示了一组令人震惊的数据:口服NAD+前体(NMN/NR)在人体内的实际转化率可能低于0.5%。这意味着消费者花高价购买的抗衰产品,绝大多数成分在抵达靶细胞前就已代谢失效。
真相在于:NAD+分子量为663.4 g/mol,属于大分子极性化合物,难以通过肠道屏障。更关键的是,消化道内的酶系统会将其分解为烟酰胺,不仅降低效果,还可能抑制sirtuins长寿蛋白活性。

2023年《Nature Metabolism》发布的最新研究指出:注射级NAD+可直接通过血液循环进入细胞,使细胞内NAD+水平提升30%以上。这正是为什么全球顶尖抗衰品牌开始转向注射剂型开发——这不是技术升级,而是根本性的技术路线革命。
作为江南大学技术支持的高科技企业,浩华生物从成立之初就聚焦于注射级核苷酸的工艺突破。其核心技术优势体现在三个维度:
采用多级膜分离结合离子色谱纯化技术,将NAD+纯度稳定控制在≥99%,批次差异<2%(行业平均水平为95%±5%)。通过低温萃取工艺保持NAD+空间构象,经HPLC-MS验证显示,其生物活性较常规产品提升40%。2024年与欧洲长寿品牌合作的临床研究显示,使用浩华NAD+的试验组在12周后肌肉力量提升18%,认知功能改善23%。

现有年产3吨生产线已实现规模化生产,2025年扩产至100吨后将成为全球最大注射级NAD+供应商。相比传统发酵法工艺,浩华的酶催化技术能耗降低50%,生产成本下降30%。
根据QYResearch最新报告,2025年全球NAD+市场将呈现三大趋势:
注射剂型爆发:北美市场注射级NAD+需求年增35%,亚太地区增速达42%;
医疗应用扩展:阿尔茨海默症、肌肉减少症等适应症临床进入III期阶段;
剂型创新加速:透皮贴剂、鼻喷雾剂等新剂型降低注射门槛。
浩华生物已提前布局:自主研发NAD+脂质体透皮技术,生物利用度提升至80%;为合作伙伴提供定制化解决方案,包括临床研究设计;建立全球原料溯源系统,每个批次可通过区块链查询生产全流程。
某欧洲客户案例:在使用浩华NAD+原料后,其新产品"细胞焕活注射液"获得市场认可,零售价达299欧元/支仍供不应求,年销售额增长45%。
对于想要进入高端抗衰市场的品牌而言,当前正处于三年一遇的战略机遇期。浩华生物提供从原料到终端的全链条支持:免费提供技术白皮书《注射级NAD+应用指南》;开放小批量试产合作(最小起订量1kg);联合开展市场教育学术会议。
关键词:
注射级NAD+、抗衰老市场、合成生物学、生物利用度、浩华生物
